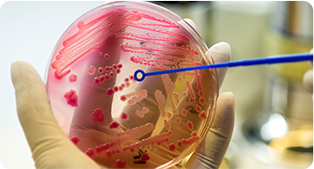

Procedimento que suaviza rugas e linhas de expressão, promovendo um aspecto mais relaxado e rejuvenescido.

Indicado para restaurar volumes, definir contornos e hidratar profundamente a pele, proporcionando resultados naturais e harmônicos.

Tratamento que estimula a produção natural de colágeno, melhorando a firmeza, a textura e a qualidade da pele de forma progressiva.

Dispositivo com microagulhas para estimular o colágeno e potencializar a absorção de ativos, promovendo renovação da pele.

Tecnologia à base de ácido hialurônico que promove hidratação profunda e estímulo de colágeno, melhorando visivelmente a firmeza, elasticidade e qualidade da pele.

Nanopartículas com alto poder regenerativo que atuam na comunicação celular, auxiliando na recuperação da pele, redução de cicatrizes e rejuvenescimento.

Terapia regenerativa à base de DNA de salmão, que estimula a renovação celular, melhora a elasticidade, hidratação e acelera a cicatrização da pele.

Tratamento de última geração que trata manchas, melhora a textura da pele e promove rejuvenescimento com mínima necessidade de tempo de recuperação.

Laser fracionado ablativo que promove renovação profunda da pele, tratando rugas, cicatrizes, poros dilatados e manchas, com estímulo intenso de colágeno.

Tecnologia versátil e não invasiva que trata queixas como manchas, melasma, vasinhos e flacidez, promovendo rejuvenescimento com segurança e resultados progressivos.

Laser de ultrassom micro e macrofocado que promove lifting sem cirurgia, melhora a flacidez e redefine contornos faciais e corporais.

Utiliza ondas eletromagnéticas para aquecer as camadas profundas da pele, estimulando o colágeno, melhorando a firmeza, a textura e reduzindo a flacidez facial e corporal.

Procedimento que realiza uma esfoliação profunda da pele, tratando manchas, acne, linhas finas e promovendo uma pele mais uniforme e revitalizada.

Aplicação de ativos no couro cabeludo para fortalecer os fios, estimular o crescimento e combater a queda capilar.

Aplicação diretamente nas áreas tratadas para auxiliar na redução de gordura localizada, celulite e melhorar o contorno corporal.

Laser de baixa intensidade que combate os radicais livres, melhora a circulação sanguínea e ainda promove mais energia e bem-estar.

Ozônio medicinal para estimular a oxigenação dos tecidos, com ação anti-inflamatória, antimicrobiana e regenerativa.

Acompanhamento médico focado na prevenção de doenças, promoção de hábitos saudáveis e detecção precoce de alterações que podem comprometer a saúde.

Avaliação completa buscando identificar as melhores opções de cuidados e procedimentos personalizados para realçar a beleza com segurança.

Estudo do perfil metabólico individual que permite identificar desequilíbrios e necessidades específicas do organismo, contribuindo para estratégias de saúde e bem-estar personalizadas.

Exame do equilíbrio das bactérias intestinais, essencial para a imunidade, absorção de nutrientes e saúde geral.
Análises que identificam predisposições genéticas e fornecem informações personalizadas sobre saúde, metabolismo, nutrição e resposta a tratamentos, auxiliando em condutas mais precisas e eficazes.

Abordagem personalizada que combina avaliação médica, estratégias nutricionais, terapias complementares e acompanhamento contínuo, promovendo perda de peso saudável e sustentável.

Dedica-se à saúde integral, com foco em prevenção, bem-estar e qualidade de vida. Realiza o acompanhamento clínico de cada paciente de forma individualizada, buscando identificar e tratar desequilíbrios de maneira ética, segura e responsável. Sua atuação é guiada pela medicina baseada em evidências e pelo compromisso com o cuidado contínuo, priorizando a promoção da saúde em todas as fases da vida.
Atende de forma integral, associando a saúde e a estética médica de maneira responsável, com avaliação individualizada e foco na promoção do equilíbrio e do bem-estar. Acredita que o cuidado verdadeiro vai além da aparência e deve refletir saúde e qualidade de vida.

“Um excelente atendimento na recepção, fui atendida no horário marcado, às recepcionista super educadas e atenciosa. A doutora Estefani dermatologista, uma ótima profissional, muito atenciosa creio que vou ver ótimos resultados no meu tratamento capilar. Muito obrigada a toda sua equipe doutora Estefani dermatologista. Eu recomendo sem dúvidas.”
“Ótima Clínica, com excelentes equipamentos.
Funcionárias extremamente educadas e atenciosas.
Dr. Neto Moreno faz uma consulta bem completa, com explicações bem didáticas e ótima atenção ao paciente.”
“Me senti muito bem recebido a começar pelas meninas da recepção muito atenciosas, Dr neto tem um conhecimento extraordinário sobre os assuntos!!! Todos estão de parabéns !!”
“Atendimento humanizado, com profissionais comprometidos com os objetivos dos pacientes.”









Com estrutura completa e uma equipe experiente, que está sempre atualizada nas
tendências e tecnologias do setor, oferecemos um atendimento exclusivo, totalmente
dedicado a quem mais importa: você.